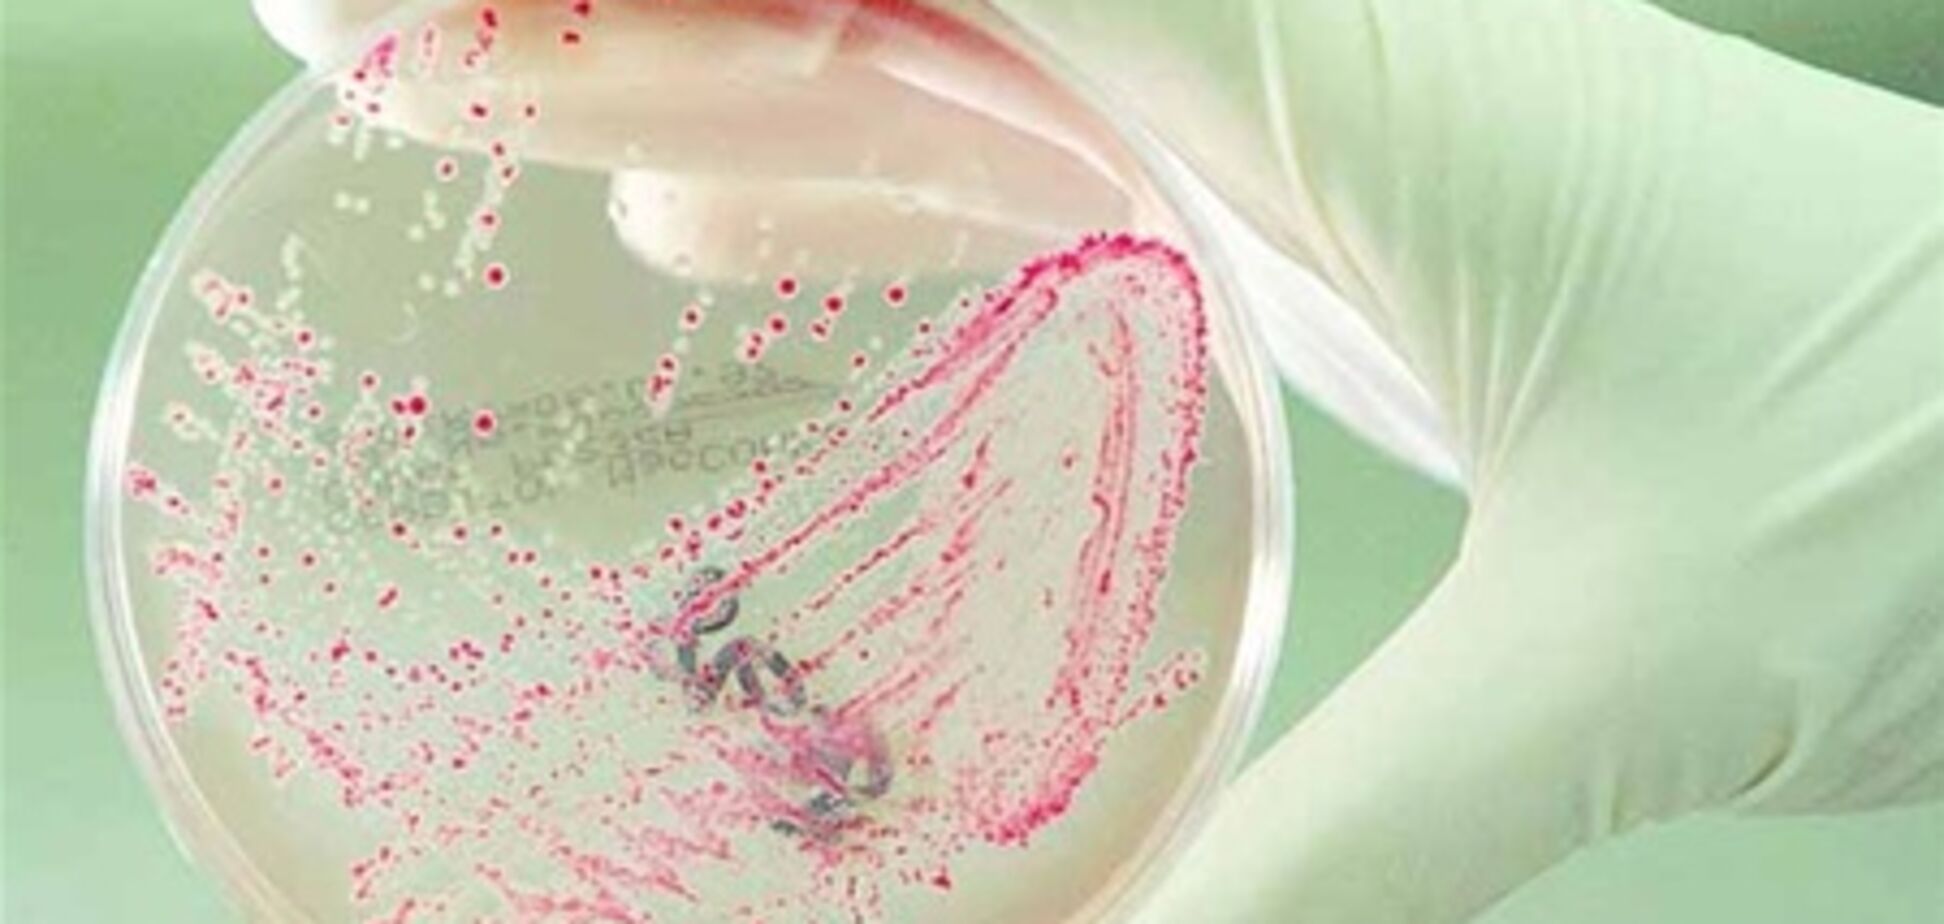
Во французском сыре нашли опасную бактерию

Во французском сыре нашли опасную бактерию
Бельгийское Федеральное агентство по безопасности продовольственной цепи (Afsca) приняло решение изъять из торговли сыр из свежего козьего молока французской фирмы Hardy из города Сель-сюр-Шер (департамент Луар и Шер).
Afsca подозревает наличие в этом сыре кишечной палочки E.coli, наводившей страх в Европе летом 2011 года, когда ее обнаружили в свежих овощах. От кишечной инфекции тогда погибло около 50 человек, пишет Интерфакс-Украина.
Федеральное агентство призывает в случае острой диареи или при наличии любых сомнений обращаться к врачу.
Бельгийским потребителям сообщены номера партий сыра и даты их продажи. Покупатели, у которых сохранился этот сыр, могут вернуть его в места приобретения для возврата денег.









